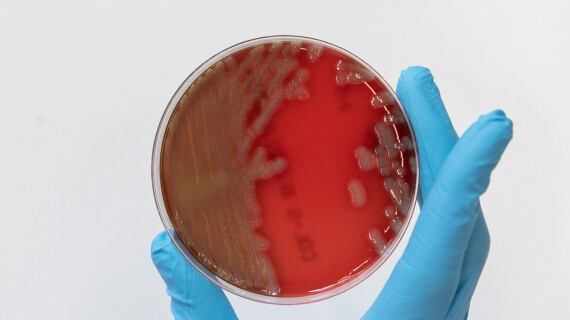
Amr-2

Our research ambitions
Diseases know no borders, they affect all of us. At ITM, we respond to the formidable challenges and opportunities in today's rapidly changing and interconnected world by:

Researching (re-)emerging infections and outbreaks
We prepare ourselves for emerging infections and future disease outbreaks.

Designing sustainable health systems and strategies
We design more sustainable health systems and (patient) care.

Accelerating disease elimination
We reduce the burden of (neglected tropical) diseases and eliminate them in specific areas or populations.
Taking on antimicrobial resistance
We address antimicrobial resistance, a global health threat, by integrating it across all three research ambitions.
Research themes

Our departments, groups and units
The activities of our three scientific departments are centered around Pathogens, Patients and Populations.

Our researchers
Our scientists and researchers all have their own fields of expertise and pursuits. They can count on the support from our administrative and technical staff.

Our laboratories
We host thirteen nationally and internationally recognised reference laboratories who contribute to scientific research and expertise in tropical medicine and infectious diseases.
Discover our research
Research themes
Over the past decades, we were able to build in-depth knowledge in several key areas.
Research projects
Through our involvement in various projects, we contribute to fundamental scientific research and capacity sharing in the world.
Research portal
Discover everything there is to know about the research areas, publications and projects of our scientists and researchers.
Partnerships around the world
We work with 24 partners across three continents to conduct joint research, develop joint course curricula and offer mobility grants to staff, to name but a few initiatives.

Library
Discover 30,000 books and e-books on tropical medicine and international health.
Datahub
Datahub offers a selection of open access materials developed at ITM and elsewhere which you can use for research and training.

Jobs and research opportunities
Browse our open positions and find a job where you can contribute to health worldwide.

Curious for more?
In Transmission, our award-winning podcast, our reseachers, physicians and partners share their personal and professional experiences as they relentlessly battle diseases and fight for a healthier world.






























































